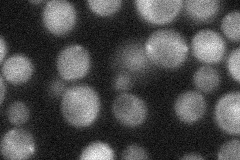
YOR126C

View description
Isoamyl acetate-hydrolyzing esterase, required in balance with alcohol acetyltransferase to maintain optimal amounts of isoamyl acetate, which is particularly important in sake brewing
Localization:
Intensity:
Fold change:
Significance:
-
C’ GFP library in SD

below threshold17.82 -
N' NOP1pr-GFP in SD

cytosol179.068 -
N' TEF2pr-mCherry in SD

nucleusN/A -
N' NATIVEpr-GFP in SD
cytosol29.8032 -
N' TEF2pr-VC and Cyto-VN in SD

#N/A0 -
C’ GFP library in SD+DTT

cytosol18.031.01No -
C’ GFP library in SD+H2O2

cytosol13.330.74No -
C’ GFP library in Starvation Media

cytosol17.340.97No -
C’ GFP library on the background of Pup2-DaMP

below threshold -
C’ GFP library on the background of CCT mutant

below threshold17.02630.954794No
